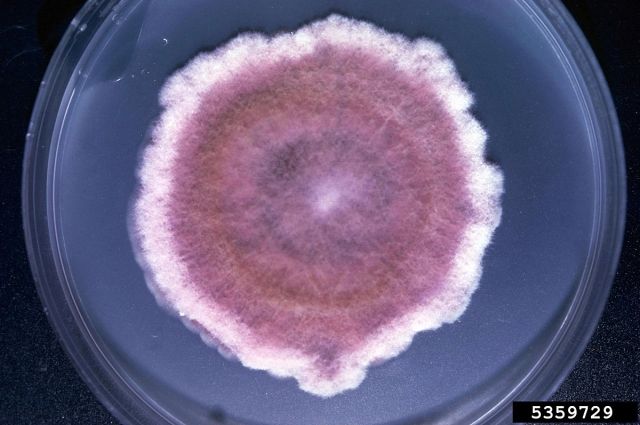

Специалистами ФГБУ «Центральная научно-производственная ветеринарная радиологическая лаборатория» при микробиологическом исследовании проб салата «Селедка под шубой» обнаружено превышение нормативного значения дрожжей и плесневых грибов.
Дрожжи - это микроорганизмы, вызывающие микробиологическую, порчу продукта. Плесневые грибы - это микроорганизмы вызывающие микробиологическую порчу продукта. Колонии дрожжей и плесневых грибов разделяют визуально. Рост дрожжей на плотных средах сопровождается образованием крупных, выпуклых, блестящих, серовато-белых колоний с гладкой поверхностью и ровным краем. Развитие же плесневых грибов на питательных средах сопровождается появлением мицелия различной окраски.
Важно, чтобы в лабораторию поступала представительная проба, которая не была повреждена или изменена при транспортировке или хранении, а отбор проб должен происходить по нормативным документам, действующим на территории государства, принявшего стандарт. Повышенное количество дрожжей и плесневых грибов- микроорганизмов порчи чаще всего свидетельствует о нарушениях правил и технологических режимов изготовления, сроков и температурных режимов хранения, транспортирования и реализации.
Более подробно читайте на сайте https://www.fgu-radiovetlab.ru
На правах рекламы
На правах рекламы

Барнаульские специалисты нашли плесневые грибы в конфетах
Барнаульские специалисты нашли плесневые грибы в конфетах  Синегнойную палочку нашли в парфюмерно-косметическом производстве
Синегнойную палочку нашли в парфюмерно-косметическом производстве  В Барнауле проверяют ветеринарно-санитарное состояние комбикормов
В Барнауле проверяют ветеринарно-санитарное состояние комбикормов  Барнаульская лаборатория мониторит производства по изготовлению консервов
Барнаульская лаборатория мониторит производства по изготовлению консервов  В Барнауле проверяют остаточное количество хлорорганических пестицидов
В Барнауле проверяют остаточное количество хлорорганических пестицидов